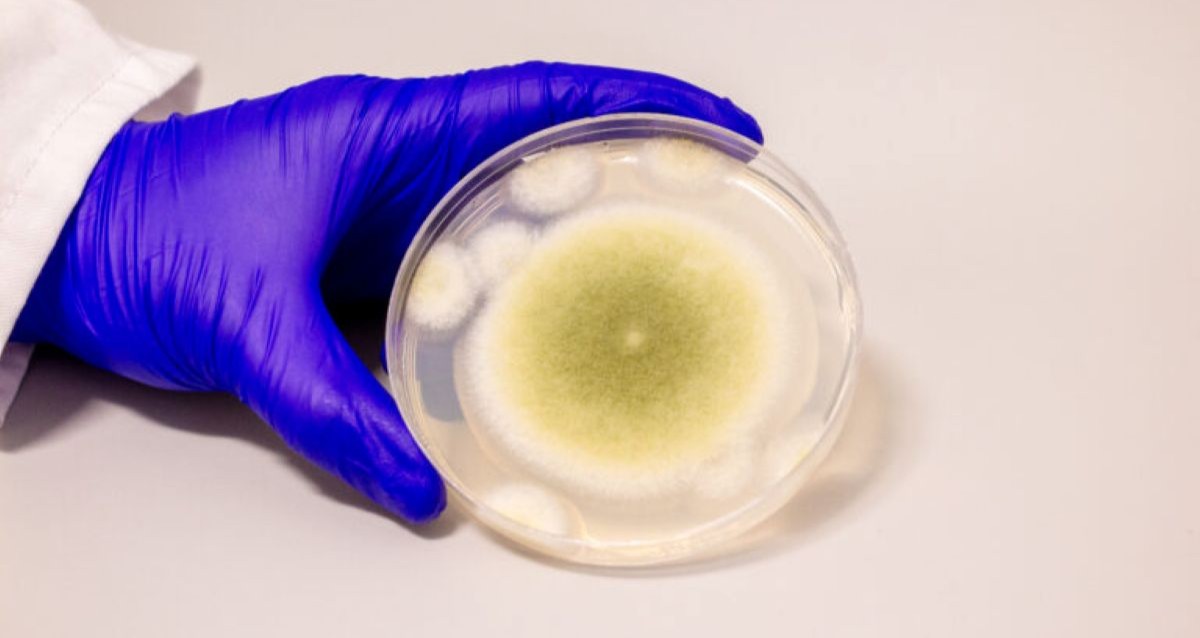
‘King Tut’s Curse’ May Be The Key To A New Cancer Treatment

Researchers at the University of Pennsylvania isolated select molecules from the fungus Aspergillus flavus and turned them into a “cancer-killing compound that rivals FDA-approved drugs.”

Wikimedia CommonsThe famous golden funerary mask found inside Tut’s tomb.
The fungus that’s believed to be responsible for the legendary “King Tut’s curse” may actually hold the secret to new, more effective cancer treatments.
Scientists have discovered a molecule within the fungus Aspergillus flavus that has opened the door to a powerful treatment for leukemia, according to a new study published in Nature Chemical Biology.
“Fungi gave us penicillin,” said Sherry Gao, associate professor of chemical and biomolecular engineering at the University of Pennsylvania. “These results show that many more medicines derived from natural products remain to be found.”
The Fungus Believed To Be Behind The “Curse Of King Tut’s Tomb”

Wikimedia CommonsJust some of the many artifacts found inside King Tut’s tomb when it was first opened in 1922.
In 1922, a team of archaeologists led by Howard Carter discovered the tomb of the ancient Egyptian pharaoh Tutankhamun, also known as King Tut. The young king’s final resting place would soon become one of history’s most captivating archaeological finds, not only because of the tomb itself, but also because of its wealth of iconic artifacts, like King Tut’s gold funerary mask.
But Tut’s tomb wouldn’t only be known for its artifacts or its historical importance. Just months after the discovery, the Earl who had financed the excavation, George Herbert, died suddenly of an infection at age 56, and to some, the circumstances seemed mysterious.
Herbert wasn’t the only person associated with the discovery to die in its aftermath. Over the next 10 years, eight other people connected to the find, including Howard Carter himself, would also be dead.
Newspapers looking to capitalize on the public’s interest in the tomb dubbed these deaths the result of “King Tut’s curse.” The story goes that the mummy cursed those who entered his final resting place.
However, modern scholarship suggests that Herbert and the others who visited Tut’s tomb had been exposed to the fungus Aspergillus flavus, whose spores can lie dormant for centuries. Those exposed to the fungus can develop a deadly lung infection, especially if they’re already immunocompromised.
This infamous fungus came up again in archaeological circles when the tomb of the medieval king Casimir IV was discovered in Poland in the 1970s. Here again, the fungus had also remained dormant inside the crypt until its discovery.
Ten members of the 12-person team died not long after the excavation. Later research confirmed that both this tomb and Tut’s contained the flavus fungus. But new research suggests that this fungus has more to offer than a deadly infection.
Why The Pharaoh’s Curse May Really Be A Cancer-Beating Cure

Bella Ciervo/UPennA sample of the Aspergillus flavus fungus.
Scientists now believe the flavus fungus can be used to treat the blood cancer leukemia. Researchers identified molecules within the fungus capable of killing the cancerous cells.
“This is nature’s irony at its finest,” Gao said. “The same fungus once feared for bringing death may now help save lives.”
Specifically, scientists isolated a compound within the fungus called ribosomally synthesized and post-translationally modified peptides, also known as RiPPs. These molecules are rare in fungi and are difficult to isolate.

Bella Ciervo/UPennResearchers carefully isolated the cancer-fighting molecules in Aspergillus flavus in order to further study them.
However, their unique shape is why they are so powerful against cancer cells. Essentially, they block the rapid, uncontrolled reproduction of cancerous cells.
Unlike chemotherapy, which harms healthy cells along with cancerous ones, scientists found that these molecules only harm cancerous cells. Unfortunately, this treatment does not work against any and all cancers, but only against specific types of cancer cells like those found in leukemia.
The research team is now looking to expand their study of the flavus fungus’ cancer-treating abilities, with the goal of eventually conducting human clinical trials. The scientists also believe other fungi may likewise contain similar life-saving compounds.
“The ancient world is still offering us tools for modern medicine,” said Gao. “The tombs were feared for their curses, but they may become a wellspring of cures.”
After reading about how the fungus behind King Tut’s curse may be a new cancer treatment, learn about the widespread fascination with ancient Egypt that’s flared up again and again throughout history. Then, delve into the life of King Tut’s wife, Ankhesenamun.